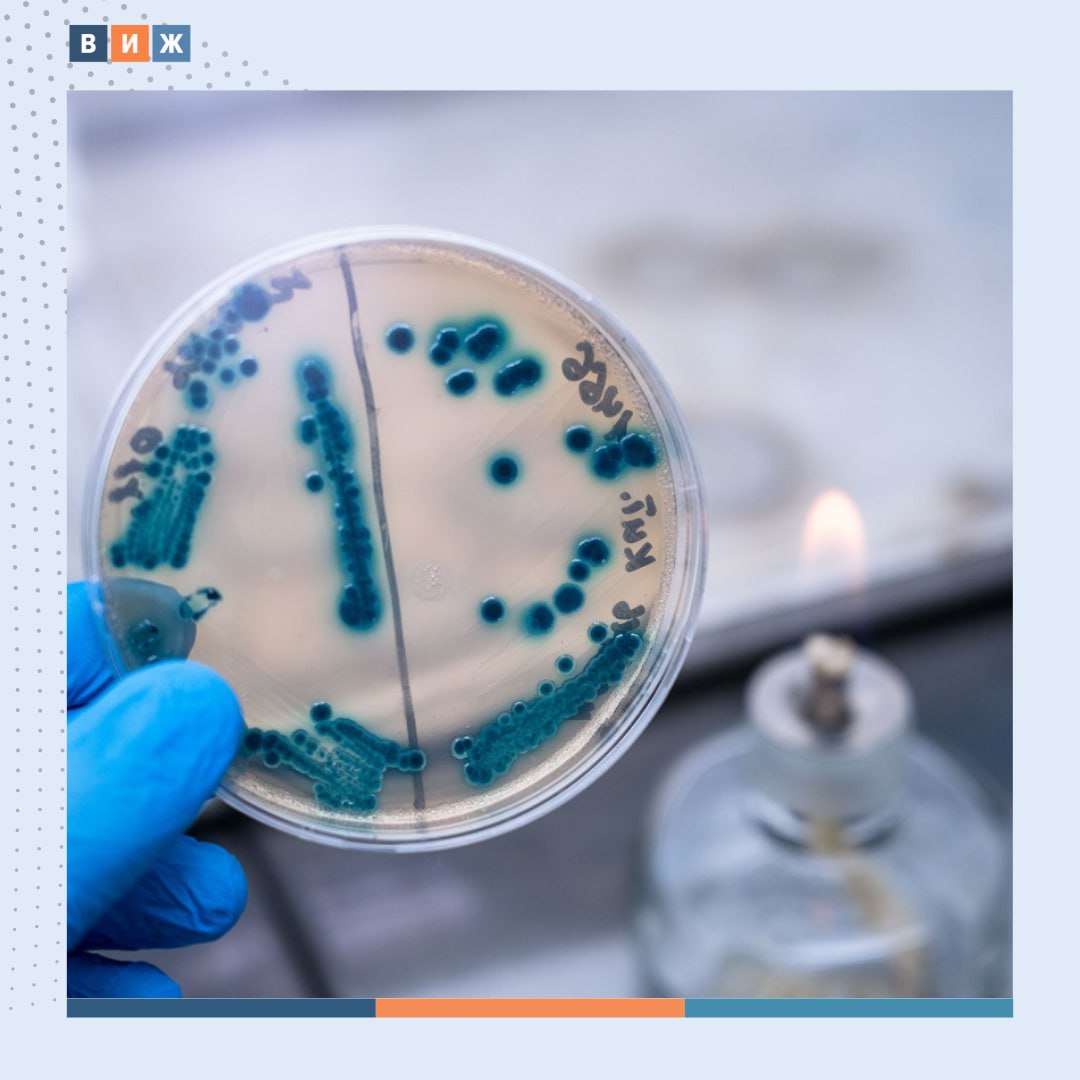
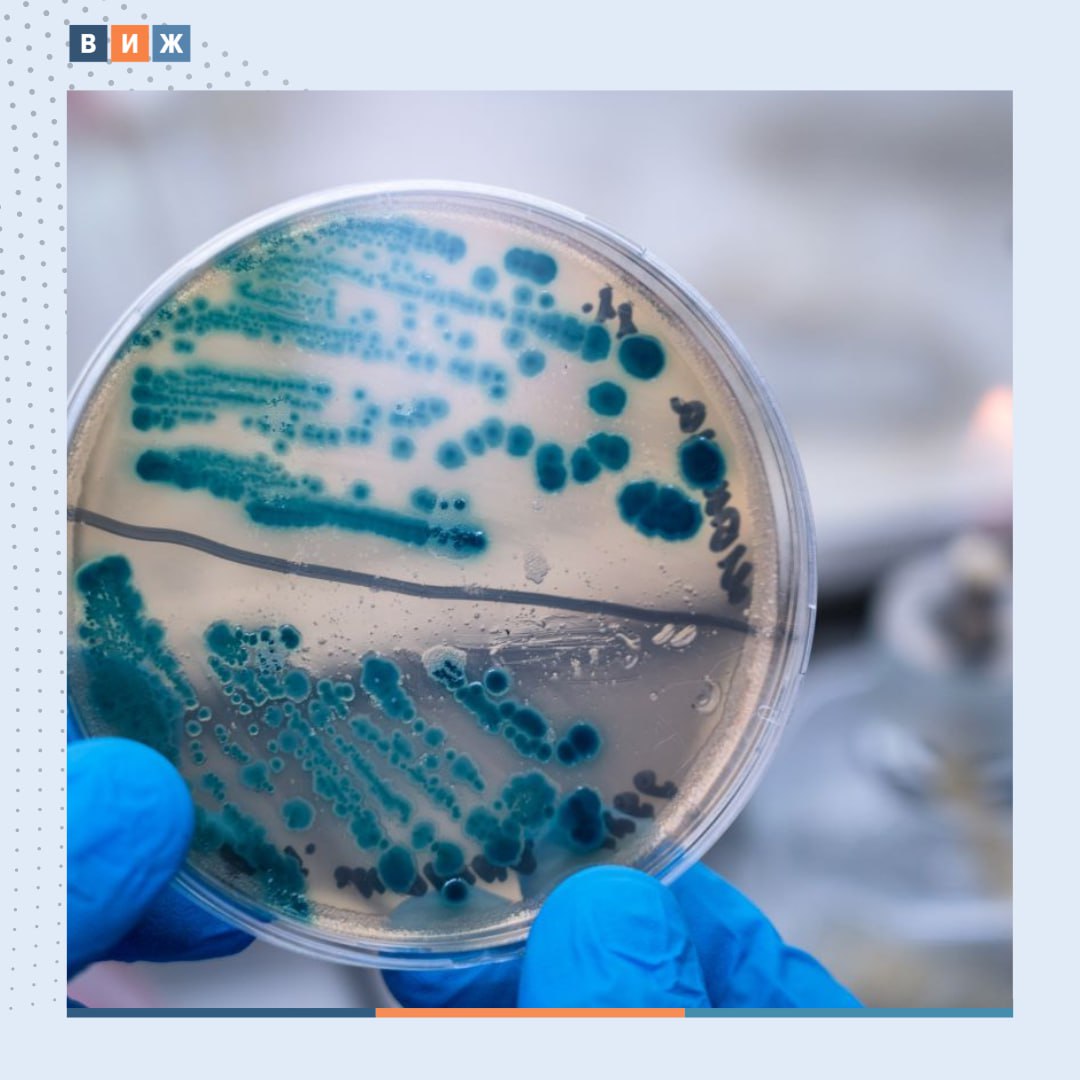
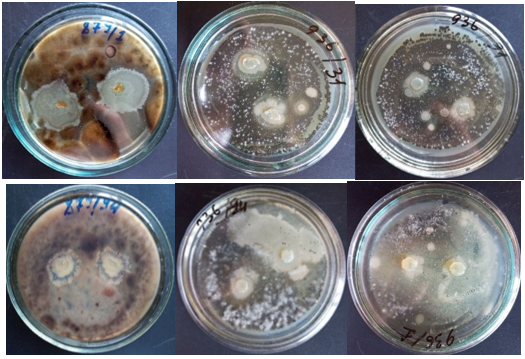
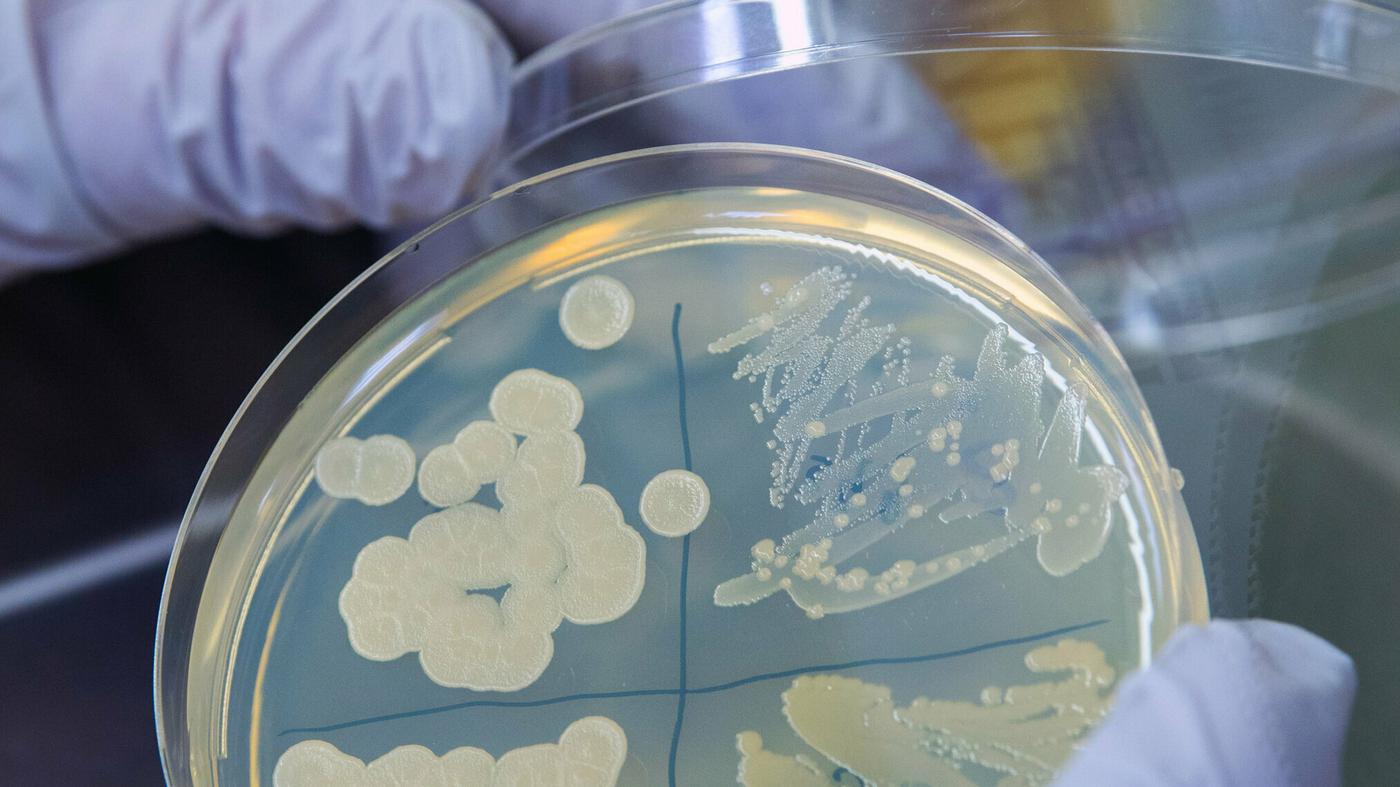

Новый штамм бактерий
Что такое датчик телефона
Какой диаметр под кондиционер
Чем побрызгать огурцы в августе
Калорийность кукурузы вареной 1
Липеры 2025 вся коллекция
Медали интернационалистам
Что используют для выпечки
Если мы встретимся то
Ротавирус от человека к человеку
Работа в валберис краснодар
Красный одинарный полнотелый
Оказалось что он
Презентации по юридической теме
Новый штамм бактерий 108 фото